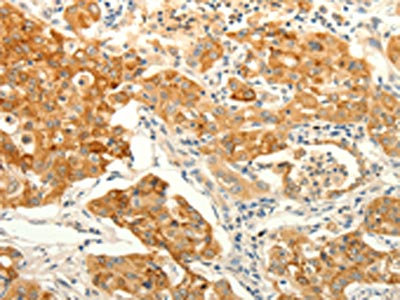

ERG Antibody
-
中文名稱:ERG兔多克隆抗體
-
貨號:CSB-PA903141
-
規格:¥1100
-
圖片:
-
The image on the left is immunohistochemistry of paraffin-embedded Human gastic cancer tissue using CSB-PA903141(ERG Antibody) at dilution 1/30, on the right is treated with fusion protein. (Original magnification: ×200)
-
The image on the left is immunohistochemistry of paraffin-embedded Human lung cancer tissue using CSB-PA903141(ERG Antibody) at dilution 1/30, on the right is treated with fusion protein. (Original magnification: ×200)
-
-
其他:
產品詳情
-
Uniprot No.:
-
基因名:
-
別名:Avian erythroblastosis virus E-26 (v-ets) oncogene related antibody; D030036I24Rik antibody; Erg 3 antibody; Erg antibody; ERG/EWS fusion gene; included antibody; ERG/FUS fusion gene; included antibody; ERG/TMPSSR2 fusion gene; included antibody; ERG_HUMAN antibody; ERG1; included antibody; ERG2; included antibody; ets related antibody; ETS-related gene antibody; KCNH2 antibody; Oncogene ERG antibody; p55 antibody; TMPRSS2/ERG fusion antibody; transcriptional regulator ERG (transforming protein ERG) antibody; Transcriptional regulator ERG antibody; Transforming protein ERG antibody; v ets avian erythroblastosis virus E26 oncogene antibody; v ets avian erythroblastosis virus E26 oncogene related antibody; v ets erythroblastosis virus E26 oncogene homolog antibody; v ets erythroblastosis virus E26 oncogene like antibody; v ets erythroblastosis virus E26 oncogene like isoform 2 antibody; v-ets erythroblastosis virus E26 oncogene antibody; v-ets erythroblastosis virus E26 oncogene homolog (avian) antibody; V-ets erythroblastosis virus E26 oncogene like (Avian); isoform CRA_e antibody
-
宿主:Rabbit
-
反應種屬:Human,Mouse
-
免疫原:Fusion protein of Human ERG
-
免疫原種屬:Homo sapiens (Human)
-
標記方式:Non-conjugated
-
抗體亞型:IgG
-
純化方式:Antigen affinity purification
-
濃度:It differs from different batches. Please contact us to confirm it.
-
保存緩沖液:-20°C, pH7.4 PBS, 0.05% NaN3, 40% Glycerol
-
產品提供形式:Liquid
-
應用范圍:ELISA,IHC
-
推薦稀釋比:
Application Recommended Dilution ELISA 1:2000-1:5000 IHC 1:25-1:100 -
Protocols:
-
儲存條件:Upon receipt, store at -20°C or -80°C. Avoid repeated freeze.
-
貨期:Basically, we can dispatch the products out in 1-3 working days after receiving your orders. Delivery time maybe differs from different purchasing way or location, please kindly consult your local distributors for specific delivery time.
-
用途:For Research Use Only. Not for use in diagnostic or therapeutic procedures.
相關產品
靶點詳情
-
功能:Transcriptional regulator. May participate in transcriptional regulation through the recruitment of SETDB1 histone methyltransferase and subsequent modification of local chromatin structure.
-
基因功能參考文獻:
- endothelial transcriptional effector activated downstream of Ang1 to promote Notch signalling and vascular stability PMID: 28695891
- Nine primary prostate cancers that developed metachronous bone metastasis samples showed TMPRSS2-ERG fusions, which were associated with increased ERG expression at immunohistochemistry. mTOR pathway activation was documented in 6 patients PMID: 30190183
- Data indicate a significant prognostic role for assessing transcriptional regulator ERG (ERG) and phosphatase and tensin homolog protein (PTEN) in men with prostate cancer. PMID: 30101374
- There was no statistically significant difference in the expression of the ERG between patients and controls. Also, no correlation was detected between the expression of this gene and age of onset, disease duration and Expanded Disability Status Scale. PMID: 29488813
- Here, the authors show that ERG, through its physical interaction with androgen receptor, induces AR aggregation and endoplasmic reticulum stress in the prostate glands of ERG transgenic mice. PMID: 28439080
- Our results suggested that reduced expression of miR-1271 may be involved in the ERG expression and that miR-1271 could be a therapeutic target for ERG-positive prostate cancer patients PMID: 28551819
- Evaluating the association between ERG expression and pathologic factors. PMID: 29948147
- despite of their well-known adverse role in prognosis of AML, neither BAALC nor ERG expression levels at diagnosis had effect on survival of AML patients who underwent allo-HSCT. PMID: 29696374
- ERG expression is lost in liver endothelial cells from cirrhotic patients with fibrosis related to alcoholic liver disease or primary biliary cirrhosis and inversely correlates with increased markers of endothelial-to-mesenchymal transition. PMID: 29026072
- ERG expression is of limited prognostic value in acute myeloid leukemia. PMID: 27935581
- Our findings indicate that TGF-beta signaling is a major determinant of EMT in T/E overexpressing LNCaP cells. PMID: 28445989
- Findings reveal that PCa-associated ERG can interact and co-occupy with BRD4 in the genome, and suggest this druggable interaction is critical for ERG-mediated cell invasion and PCa progression. PMID: 27223260
- this work provides novel insights in the regulation of ERG protein stability in prostate cancer PMID: 27626314
- Study reveals that miR-200b/a/429 is an ERG target gene, which implicates an important role in TMPRSS2/ERG-dependent PCa development. PMID: 27191272
- ERG and SOX9 are potential biomarkers for prediction of response to docetaxel treatment in metastatic castration-resistant prostate cancer patients. PMID: 27863438
- A potential novel function of TMPRSS2-ERG as a major regulator of IGF1R gene expression. PMID: 27285981
- Study shows that T2E fusion transcripts are associated with higher levels of AMACR mRNA in patients with atypical small acinar proliferation (ASAP) which represents an indicator of risk for prostate cancer in patients with ASAP. PMID: 29277318
- TMPRSS2-ERG may have a role in progression of prostate neoplasms and in alteration of the metabolic profile PMID: 27276682
- Detection of TMPRSS2-ERG in blood from Metastatic Resistant Prostate Cancer patients predicts resistance to docetaxel and it may be useful to select treatment and to avoid possible toxicities in refractory patients.TMPRSS2-ERG-positive patients had more adverse prognostic factors compared with TMPRSS2-ERG-negative. PMID: 26948395
- Meta-analysis showed the prevalence of TMPRSS2:ERG fusions in prostate cancer to be highest in men of European descent (49%), followed by Asians (27%) and then African (25%) descent. PMID: 28633309
- Data show that tumors displaying TMPRSS2-ERG fusions that retained interstitial genes were less likely to be associated with biochemical recurrence PMID: 29127096
- ERG, FLI1, TAL1, and RUNX1 bind at all AML1-ETO-occupied regulatory regions, including those of the AML1-ETO gene itself, suggesting their involvement in regulating AML1-ETO expression levels. PMID: 27851970
- four oncogenic ETS (ERG, ETV1, ETV4, and ETV5), and no other ETS, interact with the Ewing's sarcoma breakpoint protein, EWS. PMID: 27783944
- We demonstrate a role for inflammation-induced oxidative stress in the formation of DNA breaks leading to recurrent TMPRSS2-ERG gene fusions. The transcriptional status and epigenetic features of the target genes influence this effect. PMID: 27926866
- ERG signaling in prostate cancer is driven through PRMT5-dependent methylation of the androgen receptor. PMID: 27183006
- NOTCH pathway inhibition antagonizes the growth and invasion of transmembrane protease serine 2 (TMPRSS2)-transforming protein ERG (ERG) (T2E) -positive prostate cancer cells. PMID: 28783165
- findings have identified critical molecular mechanisms involving ERK-mediated ERG activation that could be exploited for therapeutic intervention in ERG-positive prostate cancers. PMID: 28887309
- Detection of Gene Rearrangements in Circulating Tumor Cells: Examples of ALK-, ROS1-, RET-Rearrangements in Non-Small-Cell Lung Cancer and ERG-Rearrangements in Prostate Cancer.( PMID: 28560674
- The TMPRSS2-ERG gene fusion is the most frequently observed genetic aberration in Prostate cancer. PMID: 28845585
- Loss of ERG is associated with prostate tumors. PMID: 28186998
- Data show that homogeneous ERG positivity is very rare in prostate cancer, especially in elderly patients. However, development of subpopulations with ERG fusions may be a much more frequent event in ERG negative cancer foci as previously believed. PMID: 27530104
- Genome-wide gene expression profiling identified a network of VEGF-responsive and ERG-dependent genes. PMID: 28536097
- ERG deletion is associated with acute lymphoblastic leukemia. PMID: 27776115
- Study provide evidence that PTEN deletion and TMPRSS2-ERG gene fusion were mutually exclusive in patients with prostate neoplasm. TMPRSS2-ERG gene fusion was rare compared to peripheral zone tumors and to PTEN inactivation in T1a transition zone tumors. PMID: 27500376
- ERG rearrangement, but not PTEN loss, is present in a minority of potential neoplastic precursor lesions in the prostate. PMID: 27189342
- Patients with Prostate cancer had significantly higher levels of the prostate cancer-associated gene ERG in post-digital rectal examination urine extracellular vesicles. Continued analysis of urine EVs offers the potential discovery of novel biomarkers for pre-biopsy Prostate cancer detection. PMID: 28419548
- loss of ERG and FLI1 might contribute to the pathogenesis of vascular lung complications through the induction of inflammation. PMID: 28248553
- Neither the expression of aberrant proteins from internally deleted allele nor the reduced expression of wild type ERG seem to provide a plausible explanation of the specific biology of ERG -related leukemia subgroup. PMID: 27494621
- Our results suggest that the immune response may differ between ERG negative and ERG positive prostatic carcinomas PMID: 28547958
- identified five phosphorylated serines on endogenous ERG in T-ALL and AML cells. PMID: 27055868
- miR-204 upregulates androgen receptor (AR ) and downregulates TMPRSS2/ERG through direct regulation of their promoter methylation and set of transcription factors during AR cancer-related reprogramming. PMID: 28050800
- differential expression of TMPRSS2:ERG in urine exosomes in prostate cancer and controls PMID: 27144529
- SPINK1 and ERG expressions are exclusive events in PCA. PMID: 27738792
- This study focused on the clinical application value of ERG methylation level in blood of pregnant women as a biomarker in Down's syndrome. PMID: 28111453
- ETV6 and IKZF1 are transcriptional regulators not just of ERG, but also of a number of genes regulated by a densely interconnected network of seven transcription factors. PMID: 27604872
- Among 98 selected prostate carcinoma biopsies, 57 showed positive and 41 negative ERG staining. PMID: 28384107
- The present study established evidence for the first two common PrCa risk variants differentially associated with TMPRSS2:ERG fusion status. TMPRSS2:ERG phenotyping of larger studies is required to determine comprehensive sets of variants with subtype-specific roles in prostate cancer. PMID: 27798103
- ERG is recruited to mRNAs via interaction with the RNA-binding protein RBPMS, and it promotes mRNA decay by binding CNOT2, a component of the CCR4-NOT deadenylation complex. PMID: 27273514
- Concurrent nuclear ERG and MYC protein overexpression is common in prostate cancer and defines a subset of locally advanced tumors. PMID: 27159573
- Studies indicate that TMPRSS2-ERG fusion gene positive prostate cancers cells rewire intracellular signaling cascades and modulate gene and protein network. PMID: 28364793
顯示更多
收起更多
-
相關疾病:Ewing sarcoma (ES)
-
亞細胞定位:Nucleus. Cytoplasm. Note=Localized in cytoplasmic mRNP granules containing untranslated mRNAs.
-
蛋白家族:ETS family
-
數據庫鏈接:
Most popular with customers
-
-
YWHAB Recombinant Monoclonal Antibody
Applications: ELISA, WB, IHC, IF, FC
Species Reactivity: Human, Mouse, Rat
-
-
-
-
-
-